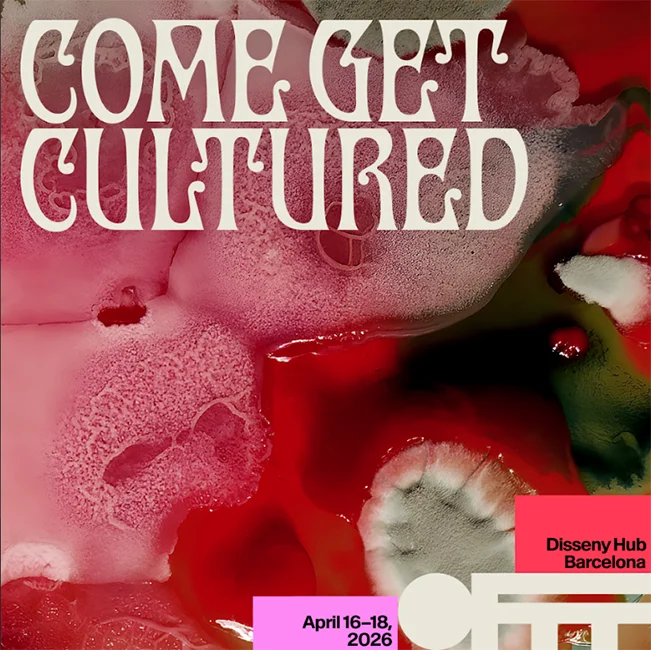
OFFF festival "come get cultured"

OFFF Barcelona 2026

OFFF Barcelona calienta motores a un mes de su 26ª edición anunciando lineup completo y nuevos formatos. El festival de arte, diseño y creatividad más importante del mundo se celebrará del 16 al 18 de abril en Disseny Hub. OFFF Barcelona reivindica su objetivo de apertura al público general con propuestas como The Screen o La Plaça Design Market.
Solo queda un mes para que OFFF Barcelona, el festival internacional más vanguardista en creatividad, arte y diseño digital, vuelva a reunir a los talentos más innovadores y destacados del sector en el Disseny Hub. Del 16 al 18 de abril el festival celebra su 26ª edición con un lineup de 45 speakers que nos descubrirán su proceso creativo en primera persona, más otros tantos workshops y masterclasses que suman un total de 95 creativos.
Este año la campaña visual “Cultured” ha sido creada por Uncommon Creative Studio. El hero film completo se desvelará el primer día del festival, presentado por Nils Leonard, fundador del estudio.
Las diversas disciplinas, experiencias y contextos creativos que convergerán este año en OFFF se unen a nuevos formatos y actividades paralelas que convertirán Barcelona en la capital de la creatividad. Esta edición contará con workshops impartidos por creativos, así como masterclasses de los líderes de industria: Adobe, Maxon, Houdini y Framer. Además, este año OFFF introduce un nuevo formato, TIPS & TRICKS, sesiones con público reducido donde 6 speakers de renombre compartirán su experiencia. Charlas cercanas en las que expertos conversarán sobre diversos temas, como dudas sobre carrera, liderazgo, reinvención profesional, etc.
Ya están disponibles en la web del festival el Full Pass, que da acceso a los tres días del festival, y los Day Tickets. Además, pronto también se podrá adquirir entrada para la jornada de clausura del día 18 de abril, que incluye la última charla de Silent Partners Studio, show audiovisual de Hamill Industries y el mapping en la fachada de Disseny Hub. Para los más fiesteros, ya está disponible la entrada para el Afterparty del 18 en La Paloma, con Dj sets de San Jones, Nahoomie y Drea.
NUEVAS CONFIRMACIONES EN EL FESTIVAL
A un mes de la celebración del festival, OFFF Barcelona ha anunciado nuevos ponentes que participarán en Disseny Hub. Entre las nuevas confirmaciones destacan referentes globales de la creatividad y la innovación visual como teamLab, colectivo japonés reconocido por sus instalaciones digitales inmersivas, y Moment Factory, estudio pionero en la creación de experiencias multimedia y entornos audiovisuales a gran escala con el Real Madrid o Madonna entre sus clientes. A ellos se suma Wieden+Kennedy Amsterdam, considerada la Agencia Global del Año 2025 por Adweek. El cartel se completa con estudios y agencias de referencia en diseño, branding y motion como FutureDeluxe, Uncommon, Hamill Industries y Base Design, que aportarán su visión sobre los procesos y tendencias que están definiendo la creatividad contemporánea.
El festival también incorpora perfiles que expanden los límites entre disciplinas, como James Beacham, físico y artista que explora la relación entre ciencia, tecnología y arte, y Johanna Jaskowska, artista digital reconocida por su trabajo pionero en estética virtual, identidad digital y cultura online. Además, el festival contará con dos paneles especiales liderados por Creative Review y Stash, dos de los medios de comunicación internacionales más influyentes. Con estas nuevas confirmaciones, OFFF Barcelona continúa consolidando un programa que reúne a algunas de las figuras y estudios más relevantes del panorama creativo global.
OFFF Barcelona, un festival abierto a la ciudad.
OFFF continúa su compromiso con la ciudad de Barcelona y presenta diferentes propuestas para convertir la ciudad en el hogar de la creatividad para acercar a todo el mundo el talento de las mentes más inquietas y crear una experiencia cultural única y enriquecedora.
Destaca un año más en la programación del festival The Screen, una experiencia de mapping en la fachada de Disseny Hub, gratuita y abierta al público durante las tres noches del festival, con una programación distinta cada noche. La muestra nace de una convocatoria abierta en la que se recibieron más de 730 obras (frente a las 350 del año pasado) de 63 países y de 5 continentes. El jueves 19 de marzo se anunciarán los proyectos seleccionados y que serán proyectados a todo el público que acuda a Disseny Hub.
The Screen también presenta obras comisionadas por el propio festival. PJ Richardson, Burton Rast, Caserne, Somnia Lab, OnionLab, Framemov crearán piezas específicas para esta experiencia de mapping. Además, Uncommon va a crear una pieza especial para el mapping en el marco de la campaña visual.
Este año, la clausura y uno de los platos fuertes del festival, los Main Titles, saldrán por primera vez a la calle y más concretamente a la fachada de Disseny Hub. PJ Richardson, director creativo estadounidense, es el encargado de diseñar este año los Main Titles, los cuales celebran “la idea de que el festival lo hacen todas las personas que asisten a él: un colectivo de creativos que se reúne para aprender, inspirarse y celebrar el diseño”.
Otra actividad abierta al público durante estos días es La Plaça Design Market. El tradicional mercadillo ofrece un año más una selección curada de 15 proyectos de diseño locales e internacionales, ofreciendo una diversa gama de productos creativos: libros, ropa, accesorios y más. Un punto de encuentro imprescindible para los amantes del diseño que deseen descubrir piezas únicas, conectar con diseñadores y experimentar lo mejor de la creatividad local e internacional.

El futuro del diseño en NXT
OFFF ofrece un prisma completo del presente del arte, el diseño y la creatividad, pero también del futuro. Para ello, el festival presenta por tercer año consecutivo NXT, plataforma dedicada a mostrar la próxima generación de talentos emergentes. En esta muestra los visitantes pueden explorar proyectos innovadores y experimentar de primera mano las presentaciones dirigidas por los estudiantes de 10 de las principales escuelas de creatividad y diseño: AMD, BAU, Brother, CTIM-UPC, Elisava, IDEP, IED, Labasad, LCI y Université de Franche-Comté. Mediante presentaciones dirigidas por los propios estudiantes, NXT brinda a los jóvenes creativos la oportunidad de mostrar sus proyectos a una audiencia global y comenzar a abrirse camino en el mundo profesional del diseño.
SOBRE OFFF
Fundado en Barcelona en 2001, OFFF es una plataforma global para la industria creativa que marca las tendencias de nuevas imágenes y estéticas en los campos del diseño, el arte y la cultura post-digital. A lo largo de sus 25 años de trayectoria, OFFF se ha convertido en una red internacional, ampliándose más allá del festival principal con OFFF On Tour, OFFF Studio y otros proyectos. Al reunir a una comunidad global de profesionales del diseño y la creatividad, OFFF fomenta la colaboración y el intercambio de ideas para expandir los límites de la cultura visual contemporánea.


Podéis obtener más información y comprar las entradas en: www.offf.barcelona















